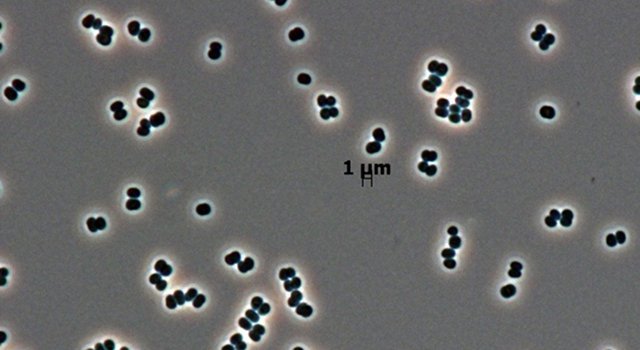
A bactéria descoberta pela NASA que pode "fingir-se de morta" e ter sido mandada sem querer para Marte

A identificação de bactérias é um desafio, pois muitas permanecem indetectáveis nos métodos tradicionais de cultura em laboratório. Em 2013, a bactéria Tersicoccus phoenicis foi detectada em salas limpas, levantando dúvidas sobre a eficiência dos protocolos de esterilização utilizados. Ela conseguiu passar sem ser detectada em protocolos de esterilização.
Segundo a Nasa, trata-se de “um micróbio raro, descoberto recentemente, que sobrevive comendo muito pouco, foi encontrado em dois lugares na Terra: salas limpas de espaçonaves na Flórida e na América do Sul”.
De acordo com estudo publicado na revista Microbiology Spectrum, “a bactéria pode entrar em um estado de hibernação profunda — um estado que impede os cientistas de detectar sua presença. Ela não está morta. Estava se fingindo de morta”.
A construção de espaçonaves exige ambientes extremamente limpos para evitar a contaminação com microrganismos terrestres. Esse cuidado é indispensável em missões que visam procurar sinais de vida fora da Terra. Como, por exemplo, sondas enviadas para buscar traços de organismos microscópicos em outros planetas. Se um micróbio fosse transportado involuntariamente para Marte ou outro corpo celeste, ele poderia comprometer resultados científicos ou até colocar em risco missões tripuladas.
Por esse motivo, as chamadas salas limpas são utilizadas durante a montagem de naves espaciais. Esses ambientes têm nível de esterilização rigoroso, sendo considerados alguns dos locais mais assépticos do planeta. Entretanto, apesar dessas precauções, a presença de bactérias resistentes continua sendo um desafio, como demonstra a recente descoberta de espécies adaptadas a sobreviver nesses locais altamente controlados. Assim, a exploração espacial depende da inovação constante nestes ambientes.
Bactérias resistentes em ambientes estéreis: como elas sobrevivem?
Mesmo com filtros de ar eficientes e uso intenso de agentes esterilizantes, algumas bactérias conseguem sobreviver nas salas limpas. Esses microrganismos, conhecidos como extremófilos, desenvolveram estratégias únicas. Uma das táticas é a formação de esporos, estruturas que protegem o DNA bacteriano contra calor, radiação e agentes químicos agressivos. Outra estratégia é o estado de dormência, permitindo que o microrganismo “finja-se de morto” diante das condições desfavoráveis e retorne à atividade apenas quando o ambiente se torna propício. Em suma, a flexibilidade desses seres permite sua persistência em locais que deveriam estar isentos de vida microscópica.
O que é a Tersicoccus phoenicis e por que preocupa especialistas?
Tersicoccus phoenicis é uma bactéria que se destacou por sua capacidade de sobreviver a procedimentos intensos de limpeza e desinfecção em ambientes isolados. Os pesquisadores descobriram que, além de resistir por longos períodos sem nutrientes, ela pode permanecer em estado dormente, sendo praticamente impossível de ser detectada utilizando os métodos convencionais. Esse fenômeno acendeu um alerta para a possibilidade de outros microrganismos passarem despercebidos, não apenas em setores aeroespaciais, mas também em áreas como laboratórios de alimentos, hospitais e indústria farmacêutica. Portanto, entender o ciclo de vida e os mecanismos de defesa dessa bactéria é essencial para evitar falhas em biossegurança.
- Resistência a agentes químicos: Muitos produtos utilizados para eliminar germes não afetam a bactéria em estado dormente.
- Capacidade de reativação: A bactéria só é “acordada” por moléculas específicas, como o fator de promoção de ressuscitação (Rpf), que são encontradas com facilidade na pele humana.
- Propagation: Ao ser reativada, pode proliferar rapidamente caso encontre nutrientes.
O conhecimento dessas características auxilia na formulação de novos protocolos e estratégias de limpeza, estabelecendo camadas adicionais de controle que vão além da detecção convencional de microrganismos. Em suma, a ciência busca antecipar as estratégias de resistência bacteriana como parte fundamental da proteção planetária.
Como as agências espaciais monitoram e enfrentam a ameaça microbiana?
As agências espaciais adotam ações rigorosas para prevenir a contaminação de sondas e espaçonaves que entram em contato direto com outros planetas ou asteroides. Esse esforço está alinhado com princípios internacionais de proteção planetária, que visam evitar a introdução de organismos terrestres em ambientes alienígenas. Portanto, cada missão espacial envolve uma série de etapas de monitoramento e esterilização.
- Monitoramento rotineiro: Superfícies e equipamentos são frequentemente analisados através de coletas e posterior cultivo microbiológico.
- Uso de tecnologias avançadas: Métodos de detecção baseados em DNA e ferramentas de análise molecular ajudam a identificar mesmo organismos que não crescem em meios convencionais.
- Esterilização intensificada: Além do calor e agentes químicos, utiliza-se radiação e luz ultravioleta para maximizar a eliminação de microrganismos.
- Desenvolvimento de novos protocolos: Pesquisadores buscam maneiras de despertar bactérias dormentes durante as etapas de inspeção, facilitando sua eliminação posterior com antibióticos e esterilizantes de amplo espectro.
Apesar dos avanços, a presença de microbiota resistente mostra que a adaptação bacteriana é um processo constante, exigindo atualização frequente das técnicas de esterilização e monitoramento. Em outras palavras, a segurança microbiológica é um objetivo móvel, o que exige colaboração internacional e integração de dados entre agências e centros de pesquisa.
Será possível eliminar completamente bactéria de salas limpas?
A erradicação total de bactérias e outros microrganismos desses ambientes ainda não foi atingida, devido à capacidade de adaptação desses seres vivos. Pesquisadores apontam que, mesmo em um ambiente sem nutrientes e sob ataques constantes de agentes químicos, algumas espécies desenvolvem formas de resistência. A diversidade microbiana nessas instalações é monitorada de forma contínua, pois sempre há a possibilidade do surgimento de novas formas resistentes.
Essas descobertas têm impacto direto nas missões interplanetárias que buscam indícios de vida fora da Terra. O risco de uma contaminação acidental levando microrganismos terrestres para outros mundos aumentou o rigor nos requisitos de limpeza e impulsionou a criação de métodos mais sensíveis de detecção. Portanto, inovação em biossegurança será vital para a exploração sustentável do espaço.
O papel das salas limpas e dos microrganismos na exploração espacial em 2025
O controle microbiano nas salas limpas continua sendo um dos principais desafios tecnológicos na era da exploração espacial. Conforme a humanidade progride na montagem de bases na Lua, na preparação de viagens tripuladas para Marte e no envio de sondas a regiões cada vez mais distantes, a atenção dada à biossegurança tende a crescer. A identificação e estudo de bactérias como a Tersicoccus phoenicis mostram que ainda existem lacunas no entendimento da resistência microbiana e reforçam a necessidade de atualização constante das práticas laboratoriais.
Tecnologias recentes, associadas ao conhecimento acumulado nos últimos anos, permitem avanços no controle desses agentes. No entanto, permanecer vigilante contra a ação de microrganismos adaptados é fundamental para o sucesso das futuras missões e para garantir a integridade dos experimentos científicos conduzidos além da Terra. Em suma, a exploração espacial demanda equilíbrio entre inovação, rigor científico e colaboração global contínua.
Perguntas Frequentes (FAQ) sobre microrganismos em ambientes espaciais
- Quais são as principais fontes de contaminação em salas limpas?
As principais fontes incluem partículas trazidas por humanos, roupas, equipamentos importados e até poeira microscópica. Portanto, o controle de acesso e protocolos rigorosos são cruciais para minimizar riscos nesses ambientes altamente sensíveis. - O que acontece se microrganismos terrestres forem encontrados em amostras de outros planetas?
Caso microrganismos terrestres contaminem amostras, poderá haver confusão nos resultados científicos, dificultando a interpretação sobre existência de vida extraterrestre. Então, equipes precisam empregar métodos avançados para rastrear a origem de qualquer contaminação. - Quais tecnologias emergentes prometem melhorar o controle microbiano em 2025?
Entre as novidades estão sensores em tempo real baseados em inteligência artificial, novos agentes antimicrobianos inspirados em peptídeos naturais, além do uso de robótica autônoma para limpeza. Em suma, essas tecnologias devem ampliar as barreiras protetivas em ambientes críticos. - É possível distinguir um microrganismo terrestre de um alienígena?
Cientistas dependem de análises genéticas e bioquímicas para distinguir entre microrganismos nativos da Terra e possíveis espécies alienígenas. Portanto, protocolos de autenticação e catalogação eficiente são essenciais em explorações interplanetárias. - Como a pesquisa sobre resistência bacteriana impacta outras áreas além da exploração espacial?
Pesquisas voltadas para o controle bacteriano em salas limpas têm impacto direto em setores como produção farmacêutica, biotecnologia e hospitais, promovendo avanços em controle de infecções e segurança em larga escala.